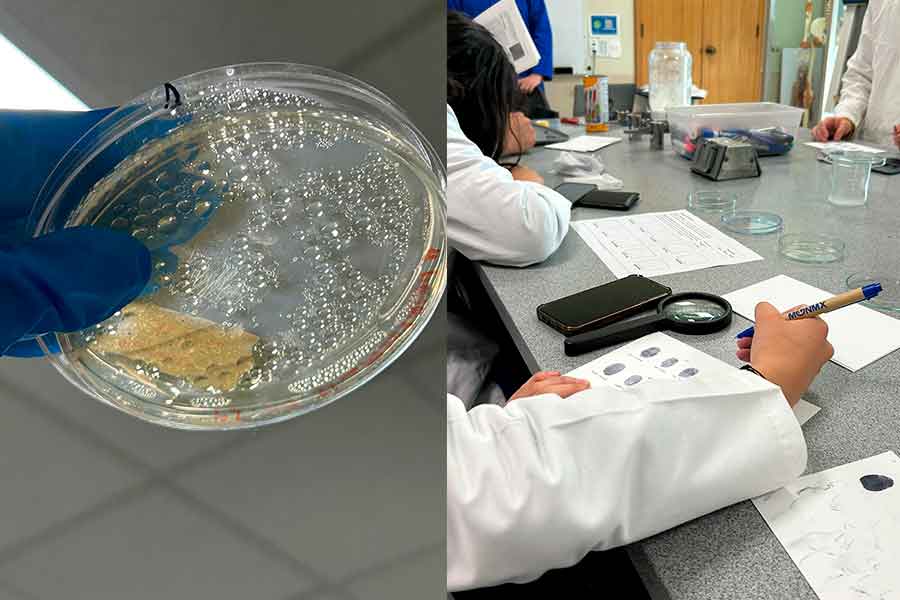
estudiante-de-prepatec-en-practicas-donde-descubrio-la-base-de-su-proyecto-para-postularse-a-programa-internacional

Sofía García Chávez, EXATEC de PrepaTec Morelia, fue admitida para participar en el International Air and Space Program, un programa en colaboración entre AEXA y la NASA.
La exalumna resultó selecta entre 50 postulantes a nivel mundial para formar parte de la edición 2025 del International Air and Space Program (IASP), donde por una semana, se les ofrecen a los participantes entrenamientos y clases impartidas por expertos en la industria aeroespacial.
“Me sentí muy emocionada al ser seleccionada, considero que es una gran oportunidad para saber en qué ámbito quiero dedicarme profesionalmente” expresó
Parte de las actividades impartidas durante el programa son:
- Simulación de gravedad cero (SCUBA),
- Talleres de rocketería y robótica,
- Entrenamiento de astronauta (Multi-Axis Trainer y moonwalking, que simula 1/6th de la gravedad) y,
- Resolución de una problemática en equipo
Esta edición se llevará a cabo las fechas del 10 al 14 de noviembre del presente año en la sede Space Center en Houston, Texas.
Del salón de clases a la NASA
Todo comenzó en las prácticas de laboratorio en el Tec, mientras trabajaba con hidrogeles, Sofía se enteró que, con ayuda de nanotecnología, se podían abrir puertas a nuevas soluciones; convirtiéndolo en la base de su proyecto.
“Cuando piensas en el espacio y astronautas, lo primero que se te viene a la mente son los ingenieros, sin embargo, mi enfoque es hacia el área de salud, considero que también es importante” mencionó
Para poder ser admitida, la EXATEC tuvo que contar con ciertos requisitos, entre ellos, postular un proyecto que brindara solución a alguna problemática relacionada al ámbito médico o aeroespacial.
“Mi proyecto se basa en ropa para astronautas a base de PET reciclado y nanotecnología para que se pudiera usar en la Estación Espacial Internacional y protegerlos de la radiación” relató
Aunque tenía dudas sobre postularse, García cuenta que el haber conocido la experiencia de participantes de la edición 2024, siendo uno de ellos Daniel Serrato, estudiante de Tec campus Querétaro, fue que se animó a continuar con el proceso; "me parece un programa increíble, aunque no estaba segura de que fuera para mí"
Adicional a esto, la egresada tuvo que mandar una carta motivo del porqué quería formar parte del programa y de su rol dentro del campo de la ciencia, además de 2 entrevistas en inglés, una para conocerla y la otra de conocimientos básicos.
Todo este proceso culminó de manera positiva para Sofía, cuando el 7 de mayo, recibió la carta de aceptación al International Air and Space Program 2025.
“Pensé que no sería seleccionada, creía que elegían a personas con muchísima preparación y experiencia profesional; aunque yo también lo estoy, no estaba segura de qué tanto” dijo
"Creo que solemos compararnos mucho, pero al final cada quién tiene su propio camino, sé único".
La constancia hace el éxito
“El haber tenido tantas oportunidades tanto académicas como extracurriculares, me ayudó a darme cuenta en qué ámbito quiero enfocarme” afirmó
Su formación personal ha sido guiada por la disciplina, constancia y ganas de superarse, al graduarse, obtuvo el mejor promedio de su generación y recibió mención honorífica de excelencia; también durante los su estancia en PrepaTec, participó en actividades como baile, se involucró en el área de salud y ciencia al ayudar a realizar el Congreso por la Salud por parte de TecMed, que la han llevado a buscar nuevos retos y espacios de crecimiento personal.
De igual manera, expresa que el haber estudiado en PrepaTec, le abrió oportunidades en diversas áreas de Arte y Cultura (LiFE) una de ellas siendo grupos estudiantiles, donde tuvo diferentes roles como mesa en grupos como Kino, De Raíz y Carneros.
“Me encantaría seguir buscando este tipo de oportunidades para crecer y llegar a realizar investigaciones para impactar en la vida de las personas” complementó
Sofía también destaca el apoyo de su mamá, quien le ha enseñado de resiliencia y siempre dar lo mejor de ella, “si no pudiste lograr algo, quizá sea para ti, pero en otro momento. Mientras tanto, hay más oportunidades allá afuera; depende de ti tomarlas.” puntualizó
También te podría interesar: